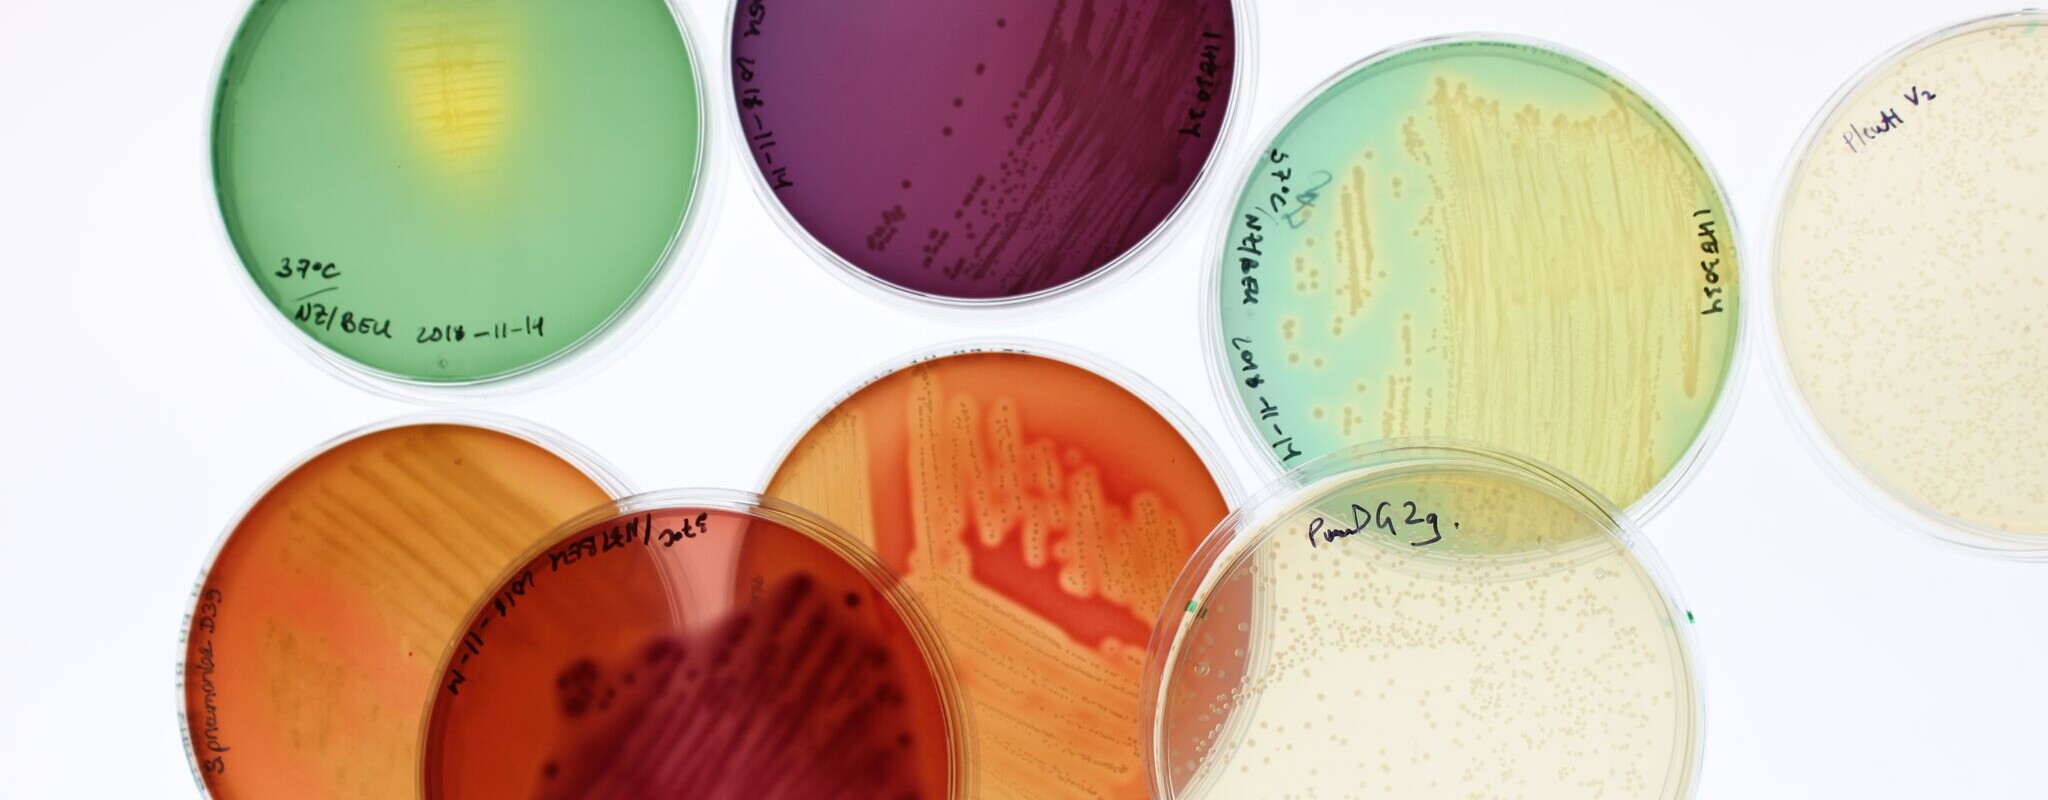
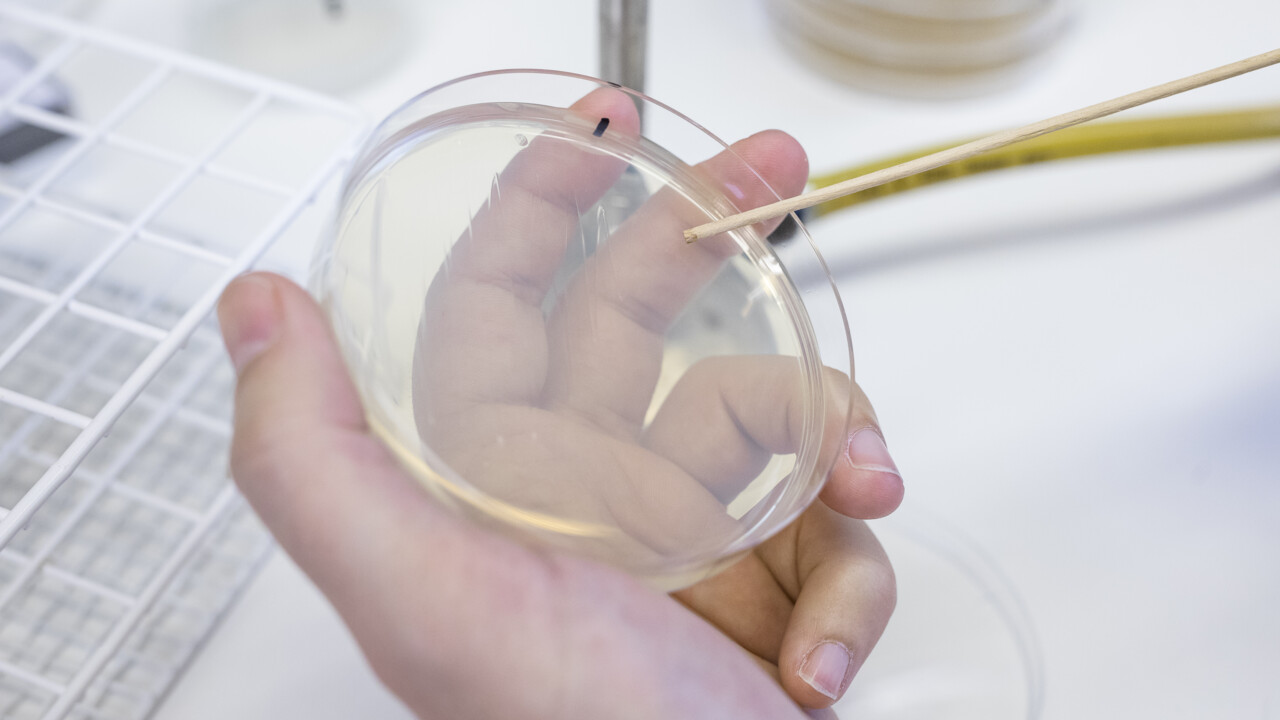
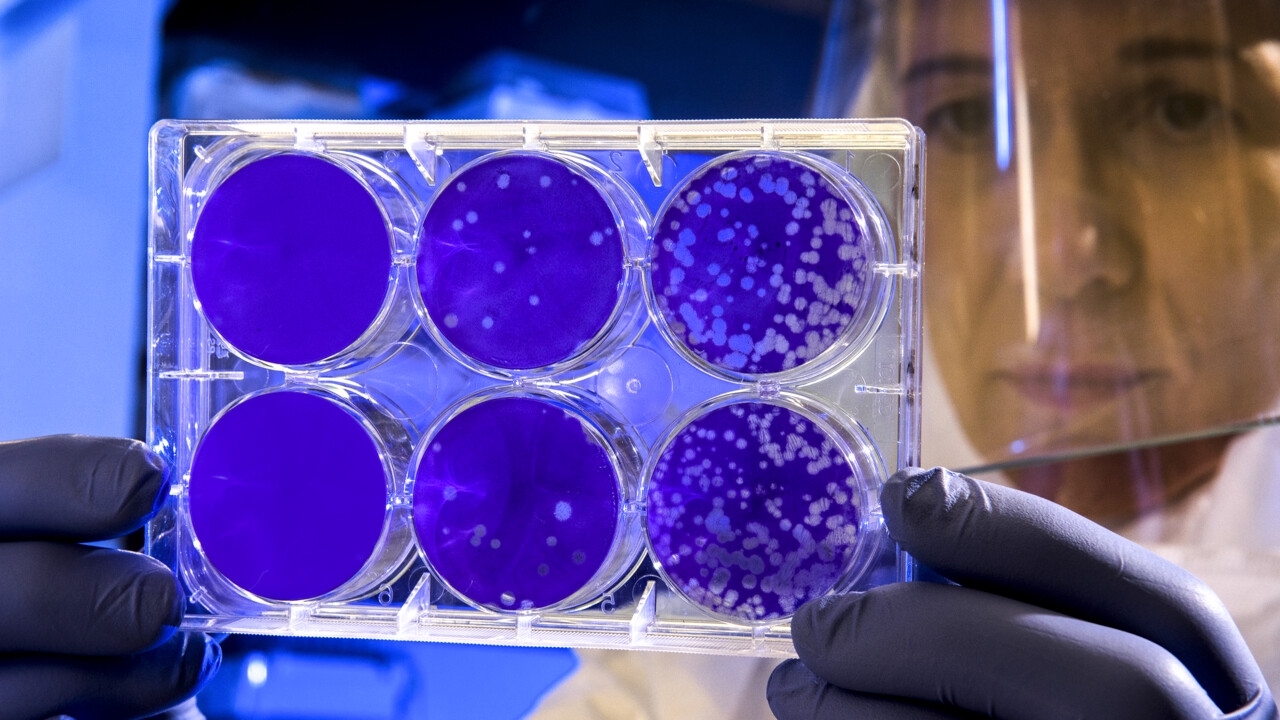

Bild: Nikola Zlatkov Kolev
Du surfar just nu på en begränsad version av umu.se. Vad innebär det här?
Bild: Nikola Zlatkov Kolev
Infektionsbiologi är läran om hur olika patogener – virus, bakterier, svampar, parasiter – infekterar och koloniserar celler, vävnader och organ. Här ingår även forskning om de molekylära mekanismer som leder till sjukdom hos människor, djur och växter i samband med infektion. Inom ämnet ryms också forskning om smittspridning, vacciner, läkemedel och resistens. Covid-19-forskning är ett prioriterat område.
Möjligheterna att behandla bakterieinfektioner har minskat efter lång tids överutnyttjande av antibiotika.
Hur är virus är uppbyggda, hur förökar de sig, hur orsakar de sjukdom och kan de omprogrammeras?

Parasiter är en bred gruppering organismer som orsakar allt från dödliga sjukdomar till harmlösa åkommor.

Forskare studerar svamparnas patogenitet i syfte att kunna utveckla bättre svampdödande läkemedel.

Immunförsvar och inflammatoriska processer skyddar mot bakterier, virus och andra ämnen.

Antimikrobiell resistens är ett globalt folkhälsoproblem som ökar med oroväckande hastighet.

Kemiprofessor representerar Umeå universitet i Kungl. Ingenjörsvetenskapsakademin, IVA.

Tre unga forskare är utsedda till Wallenberg Academy Fellows av Knut och Alice Wallenbergs Stiftelse.

Möt Sanja Vanhatalo, postdoktor i Björn Schröders labb, som studerar mikrobiota och tarmsjukdomen IBD.

Max Renner undersöker hur virus kopierar sig själva - för att kunna stoppa framtida utbrott.

Infektionsforskaren Anne-Marie Fors Connolly, får 500 000 kronor i investeringsmedel av Alf-kommittén.

Forskarnas mål är mer träffsäkra läkemedel med lägre doser och mindre påverkan på frisk vävnad.

Covid-19-forskning är prioriterad och högaktuell vid Umeå universitet.